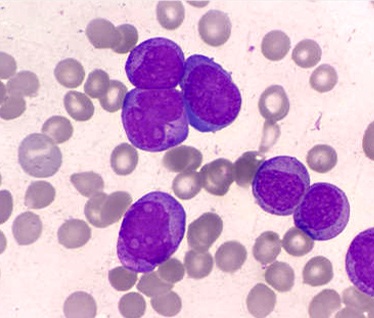
Picture of Stem Cell Therapy

Rated #1 in New York for
Total Ankle Replacement Surgery

Raymond J. Walls, MD
FAAOS, MFSEM, MRCSI, FRCS(TR & ORTH)
International Board Certified & Fellowship Trained Orthopaedic Surgeon
FOOT & ANKLE RECONSTRUCTION, TRAUMA & SPORTS INJURIES
Dr Raymond Walls is a Board Certified Orthopaedic surgeon with specialist Fellowship training in Foot and Ankle surgery. He has received extensive training throughout Europe and the United States and is expert in minimally invasive arthroscopic techniques and adjunctive therapies including PRP and Stem cell augmentation.
About Dr. Walls →
Areas of Expertise
Dr Walls offers comprehensive care for a wide range of foot & ankle conditions using advanced non-surgical and surgical treatments. Please click on the links below for more information.
Regenerative Orthopaedics
Enhance the Natural Healing Process
Dr. Walls In The News

50 orthopedic surgeons to know in 2023
Raymond Walls, MD. NYU Langone Hospitals (New York City). Dr. Walls is a professor in the orthopedic surgery department at the NYU Grossman School of Medicine. In 2008, he received an award from the British Association for Surgery of the Knee for his study showing how neuromuscular electrical stimulation before knee replacement surgery can strengthen patients’ muscles and accelerate recovery. Know More

Academic Publications
Peer Reviewed Original ResearchValidation of the Foot And Ankle Outcome Score (FAOS) for Ankle Osteochondral Lesions
Patient Education & Resources
Explore this section for resources
Contact Dr. Walls
Schedule an Appointment to Receive Specialist Orthopaedic Care for Foot & Ankle

Manhatten Office
1171 Delancey Street, New York, NY 10002
Tell :
Book an Appointment →
Staten Island Office
1534 Victory Boulevard, Staten Island, NY 10314
Tell :
Book an Appointment →
Midtown East Office
645 Madison Avenue, 3rd Floor, New York, NY 10022
Tell :
Book an Appointment →